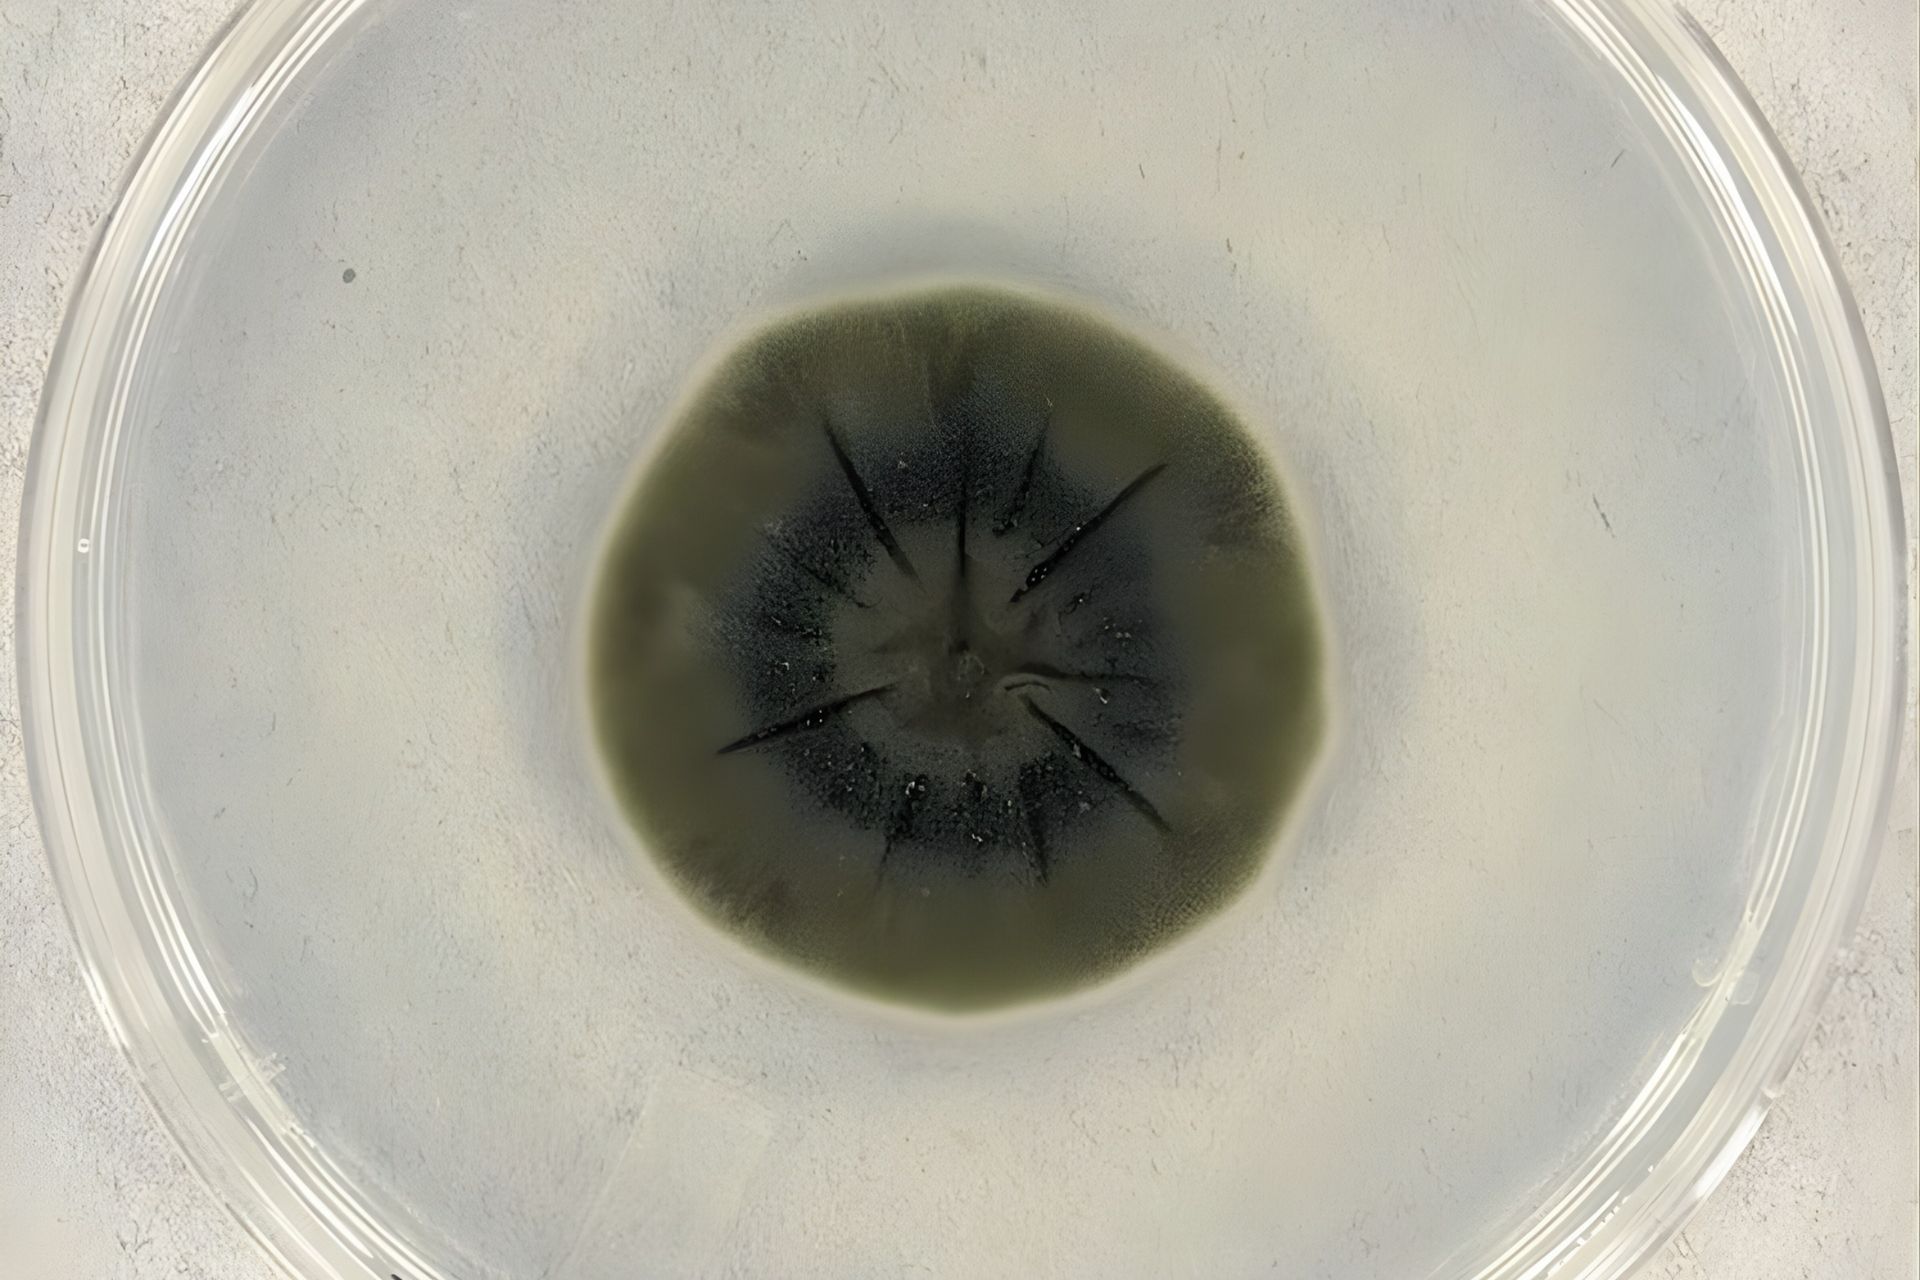

This Supreme Court decision could turn off your internet

Designed by NextGen News
Now Sony really wonβt want you to pirate those new episodes of Pluribus. On Monday, the Supreme Court heard arguments in a billion-dollar digital piracy case that will decide whether internet service providers (ISPs) can be held responsible for customersβ illegal downloads.
What does that have to do with your internet?
It all stems from a high-stakes legal battle between Cox Communications, which is one of the largest ISPs in the US, and Sony that goes back years:
In 2019, a court ordered Cox to pay Sony $1 billion, stating the ISPβs inaction allowed users to download over 10,000 pirated songs.
Shortly after, an appeals court tossed the $1 billion in damages and called for a new trial, leading Cox to turn to the Supreme Court.
Why wouldnβt Cox want the $1 billion tossed? Well, the ISP argued that it engaged in βwillful contributory infringementβ and said it shouldnβt be liable for actions its customers take. Cox also warned SCOTUS that a retrial could lead to an even larger penalty.
That leads us to today (and the internet issue): Sony and a group of other music labels argue that Cox should be liable for repeat copyright violations by its users, while Cox says that such a ruling could force ISPs to cut off internet access for millions of Americans.
Piracy is a big issue⦠for some
Almost all internet service providers are part of a voluntary alert system to crack down on piracy, but Cox, the USβs third-largest broadband provider, is not. However, thatβs not the main reason Sony is going after Cox:
Sony and the music labels argue that Cox ignored repeated alerts about customer piracy, noting that the DMCA made it illegal to download and distribute copyrighted music online (read here).
The group of labels even cited an internal email in which a Cox manager quite literally wrote, βF the dmca!!!β
Coxβs response? Cox argued that courts have typically said contributory infringement only applies when companies knowingly push for illegal activity, something it says it never did.
Piracy is a big deal: In 2023, pirated movies and TV shows were downloaded nearly 19 billion times, costing the US economy over $29 billion, while music piracy sites drew more than 17 billion visits.
But, if you still want to pirate your favorite songsβ¦ donβt worry, because SCOTUS isnβt expected to decide on the case until this summer.

Hong Kong launches investigation into deadly apartment fires

Dale De La Rey / AFP via Getty Images
The incident is the deadliest fire in Hong Kong in decades. Hong Kong officials are forming an independent investigative committee to investigate last weekβs apartment complex fire that left over a hundred people dead.
What happened?
Last Wednesday, a massive fire broke out at the Wang Fuk Court residential complex in Hong Kong, engulfing scaffolding and rapidly spreading through seven of its eight towers (see map, photos, and videos).
The blaze claimed at least 159 lives, the youngest being a one-year-old infant, and over 40 people are still missing as of this writing.
Authorities say the fire spread extremely quickly due to the use of substandard materials during a renovation project, including exterior scaffolding, protective netting, and flammable external foam panels.
Safety checks were ignored. Investigators say several netting samples didnβt meet safety standards, leading officials to claim contractors misled inspectors to save money. The labor department had conducted 16 inspections since July 2024, including one just a week before the fire, and assured residents who reported hazards that the risk of a fire was unlikely.
Public outrage is mounting
The blaze has pushed tens of thousands of Hong Kong residents to demand transparency and question fire-safety rules after earlier concerns from civilians were largely ignored, or worse:
Residents at the Wang Fuk Court complex had reportedly raised safety complaints about the protective netting for over a year, investigators found.
Officials also declined to comment on reports that civilians were arrested over the weekend after demanding accountability for the fire, a result of Chinese national security laws imposed in 2019 that can effectively criminalize free speech and protests.
Rising demands for accountability among residents were met with two separate warnings from Chinese national security authorities, claiming βanti-Chinaβ forces are using the fire to sow division.
What happens now? City officials have vowed to conduct a judge-led independent review of building-safety regulations and enforcement practices across Hong Kongβs construction industry. Additionally, more than a dozen people tied to the buildingβs renovation have been arrested on suspicion of manslaughter.

OpenAI declares βcode redβ as its rivals gain ground

Designed by NextGen News
Altman just hit the panic button. Earlier this week, OpenAI CEO Sam Altman issued an internal βcode redβ order directing staff to urgently improve ChatGPT as the companyβs rivals increasingly catch up in the AI race.
Pedal to the metal
The directive, delivered in a memo to staff, instructs the company to prioritize enhancements to ChatGPTβs speed, reliability, personalization, and total capability. The memo also called to expand the chatbotβs global audience, which is already used by 800 million people each week.
As part of the code-red effort, OpenAI is effectively pausing work on several of its other planned projects:
Work on AI agents, health and shopping features, a personal-assistant product known as βPulse,β and advertising initiatives is now delayed indefinitely.
In addition, employees who are working on ChatGPT are now expected to attend a special daily call in an effort to coordinate collaboration and resources.
Why is OpenAI ringing the alarm bell?
The push comes in response to mounting competition from Googleβs new AI model, Gemini 3, which recently outperformed ChatGPT on key industry benchmarks and garnered a whole lot of attention:
Google reports that its Gemini app grew from 450 million monthly users to over 650 million in just three months, largely fueled by the August debut of its viral AI image generator, Nano Banana.
Industry sources say Googleβs recent rise represents one of the most decisive signs yet that OpenAIβs early lead in generative AI has finally begun to narrow.
And itβs not just Google OpenAI has to worry about: AI startup Anthropic has also seen rapid growth, expanding from under 1,000 enterprise users just two years ago to over 300,000 in September, and is expecting to bring in $70 billion in revenue by 2028β¦ all while OpenAI is yet to be profitable.
In partnership with Roku
Shoppers are adding to cart for the holidays
Over the next year, Roku predicts that 100% of the streaming audience will see ads. For growth marketers in 2026, CTV will remain an important βsafe spaceβ as AI creates widespread disruption in the search and social channels. Plus, easier access to self-serve CTV ad buying tools and targeting options will lead to a surge in locally-targeted streaming campaigns.
Read our guide to find out why growth marketers should make sure CTV is part of their 2026 media mix.

Move over, Boeing, Airbus is now the one with plane problems

Eric Piermont / AFP via Getty Images
About time Boeing found a successor. Airbus recently reported a slew of issues across its A320-family aircraft, sending its stock into a nosedive and instantly making the manufacturer the latest poster child for aviation woes.
Perpetual problems
Boeing has been the face of plane problems for the vast majority of recent years (think two fatal 737 crashes, the door plug incident, and ongoing production flaws), but Airbus might take the cake, at least for now:
Last week, the planemaker was forced to recall 6,000 A320-family aircraft due to a major software glitch.
Investigators suspect the glitch triggered a sudden altitude drop on a Cancun-to-Newark flight in October, injuring over a dozen passengers who were later hospitalized.
Then, on Tuesday, Airbus said that it will inspect hundreds of its A320 planes after discovering some of them might have a faulty fuselage panel due to a βsupplier-quality issue.β
Itβs no small issue
Airbusβs A320s have recently dethroned Boeingβs 737s as the worldβs bestselling aircraft, so last weekendβs recall had widespread effects at airports worldwide:
The issue grounded more than 500 US aircraft and forced JetBlue to cancel 70 flights.
Overseas, dozens of flights were canceled in New Zealand, Japan, and Germany, and Colombiaβs Avianca froze ticket sales until December 8.
Looking ahead: Airbus lowered its 2025 delivery target from 820 aircraft to roughly 790 amid the fuselage panel problem on Wednesday, though the planemaker hasnβt changed its financial forecast for the year.

This black Chernobyl fungus might eat radiation
Medmyco / Wikimedia
This thing will turn into an existential threat before we know it. Scientists have found a dark fungus thriving in the ruins of Chernobylβs reactors that feeds on lingering radiation. What could possibly go wrong?
Nukes for breakfast
In 1986, Chernobylβs nuclear plant exploded in one of historyβs worst disasters, turning the city into a ghost townβ¦ except for a newly discovered fungus.
Unlike nearly all organisms that die under intense radiation, these fungi not only survive in its presence, but prefer it:
Scientists noted that the fungus, named Cladosporium sphaerospermum, spreads rapidly when exposed to ionizing radiation, even growing faster than it does under βnormalβ conditions.
How is this possible? Researchers hypothesize that these fungi could use a process called βradiosynthesis,β where melanin in their cell walls absorbs ionizing radiation and converts it to energy.
Why is this important?
If the hypothesis is confirmed, the adaptation would challenge assumptions about how life can survive in extreme radiation and give scientists an example of biological resilience that was long thought impossible.
However, beyond biology, the fungus has some exciting potential realβworld applications:
Researchers are exploring whether similar fungi could be used in bioremediation, or the ability to clean up radioactive waste that is toxic for humans.
On the ISS, melanized fungi exposed to cosmic radiation showed early signs of acting as a biological radiation shield, hinting at potential uses for long-duration missions to the Moon, Mars, or beyond.
Despite all of the excitement, thereβs still a big caveat: Scientists donβt actually know whether melanized fungi can turn radiation into energy. While experiments show they grow faster and survive better when exposed to radiation, researchers havenβt yet proven that they use it to power real metabolic processes, like how plants do using photosynthesis.
How did you like today's newsletter?

Catch up on this weekβs weird news

Zootopia 2
> Zootopia 2 brought in $556 million internationally over Thanksgiving weekend, setting a new record for the biggest global opening for an animated film and marking the highest opening for any movie this year.
> The House Oversight Committee has released never-before-seen photos and videos from Epsteinβs two private islands, showing bedrooms, bathrooms, a pool, a dental-style room with hanging masks, and more.
> According to a new study that used data from over 10,000 children, kids who got their first smartphone by age 12 had a 31% higher risk of depression, 40% higher risk of obesity, and 62% higher risk of not getting enough sleep.
> The average price of a large cheese pizza in the US has soared to $17, according to the online ordering platform Slice, mainly due to a rise in ingredient, labor, and delivery costs.
> A record 202.9 million Americans shopped from Thanksgiving Day through Cyber Monday this year, the largest number ever recorded by the NRF.






